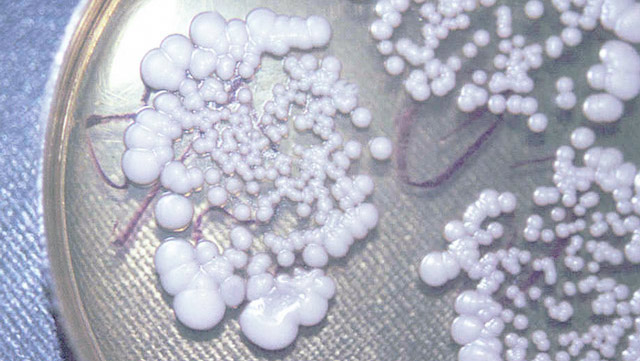

Народные средства
Для смягчения проявлений грибковой инфекции в горле во время лечения препаратами можно прибегнуть к использованию народных средств.
Следует отметить, что самостоятельное лечение без использования специальных препаратов от грибков не способствует полному излечению. Народные средства способствуют выводу из организма антител, направленных против патогенных грибков (чтобы предотвратить возможное отравление), и улучшают общее состояние пациента.
Для достижения желаемого результата рекомендуется использовать все домашние лекарства в течение не менее 14 дней.
Для борьбы с грибком в полости рта можно воспользоваться народными средствами, такими как лекарственные травы и определенные продукты. Ниже приведены несколько рецептов:
- Смешайте по 5 г измельченного зверобоя, дубовой коры и листьев брусники. Залейте все 1 стаканом кипятка и настаивайте средство 3 часа. Процедите снадобье и используйте для полоскания ротоглотки не менее трех раз ежедневно до полного выздоровления.
- Сок лимона (из половины фрукта) соедините с ½ ч.л. сока золотого уса. Полученным средством обрабатывайте слизистую воспаленной ротоглотки 2 раза каждый день. Применяйте снадобье по необходимости для облегчения симптомов фарингомикоза.
- Заварите стаканом кипятка 1 ст. л. сухих цветков ромашки. Настаивайте 60 минут, процедите. Полученный настой используйте для орошения или полоскания глотки до 5 раз ежедневно. Применять средство можно неограниченное время для обеззараживания полости рта.
- Смешайте по 1 ст. л. сухие цветки календулы и листья перечной мяты. Залейте сырье водой (300 мл), поставьте на огонь, доведите до кипения. Через 3 минуты состав снимите с плиты и остудите. Процеденным отваром промывайте ротоглотку 2-3 раза ежедневно.
Лечение
Эффективное лечение грибковых инфекций позволяет пациенту выздороветь в течение 2—3 недель. В случае серьезного прогрессирования заболевания может потребоваться хирургическое удаление пораженной ткани и проведение эндоскопической очистки носовых пазух.
Для предотвращения повторных случаев назначается повторная проверка через 4 месяца, но не позже, чем через полгода.
Медикаменты
При своевременном обращении к врачу, лечение можно провести дома. Врач может рекомендовать использование местных капель и мазей, а также назального спрея.
Из препаратов против грибковых инфекций часто применяются азолы, которые уничтожают клетки грибов: Интраконазол, Флуконазол, Бифоназол, Клотримазол. При обнаружении золотистого стафилококка используют Нистатин, Леворин. Для очистки пазух, пораженных гистоплазмозом или мукоромикозом, применяют раствор препарата Амфотерицин.
Для уменьшения проявлений аллергической реакции врачи назначают десенсибилизирующие препараты, для облегчения дыхания используются сосудосуживающие аэрозоли, а для укрепления иммунитета — витаминные комплексы.
Народные методики
Использование как аптечных, так и домашних противогрибковых средств способствует более быстрому восстановлению здоровья.
- Рекомендуется промывать носовые пазухи природными настойками. Для этого необходимо залить столовую ложку сухой травы череды, коры дуба, цветков ромашки, шиповника, календулы (на ваш выбор) стаканом кипятка и настоять в течение 3 часов. Полученную жидкость следует использовать для промывания носа 3—4 раза в день.
- Свежевыжатые соки моркови или свеклы могут быть использованы в качестве противогрибковых капель для носа, их следует закапывать до 4 раз в день.
- Ежедневное применение масляных компрессов способствует более быстрому отслоению корочек и заживлению ранок. Ватные или марлевые тампоны следует смочить в масле облепихи, смеси масел чайного дерева и оливкового, ввести в каждую ноздрю и оставить на полчаса.
- Для дезинфекции и снятия отечности рекомендуется прополаскивать носоглотку слабым раствором соды или соли (четверть чайной ложки сухого ингредиента на стакан воды). Можно чередовать различные виды полосканий. Рекомендуется провести 5—6 процедур. Эффективно обрабатывать носовые пазухи раствором, состоящим из той же пропорции морской соли и нескольких капель йода. Жидкость следует набрать в небольшую резиновую грушу или шприц (без иглы) и ввести в полость.
Симптомы и признаки
Появление грибка в носу сопровождается определенными признаками:
- интенсивный зуд, который раздражает слизистую оболочку носа и вызывает отёчность. Неприятные ощущения усиливаются, когда человек находится в сухом помещении, а также после применения капель, сужающих сосуды;
- постоянное чихание, которое не прекращается в течение трёх недель из-за обильного скопления слизи в носовых ходах;
- выделения из носа различной консистенции и оттенков. В отличие от вирусной инфекции, выделения не уменьшаются, а только усиливаются, имеют неприятный запах;
- заложенность и отёчность носа. Применение капель и спреев временно облегчает неприятные симптомы. Однако отек слизистой носа может привести к недостатку кислорода, вызывая раздражительность;
- головная боль.
В носовой полости обитает несколько разновидностей грибков, и у каждого из них свои особенности проявления:
- Золотистый стафилококк. Начальные симптомы этого заболевания включают обычный насморк, который со временем становится зеленовато-жёлтым из-за присутствия гноя. Появляются гнойники в носовом проходе, а пациент перестает ощущать запахи. Голос становится хриплым, и больному становится трудно дышать, из-за чего он вынужден чаще использовать рот для вдыхания кислорода. Резкое повышение температуры тела может привести к осложнениям, таким как воспаление гортани или бронхит.
- Риноспоридиоз. Это заболевание вызвано грибами, которые обитают в воде и воздухе. Пациент жалуется на головные боли и выделение слизи из носа, иногда с кровотечениями из носоглотки. Это может привести к образованию полипов в носовой полости, что затрудняет нормальное дыхание.
- Кандидоз. Выделения из носа при этом заболевании напоминают творожную массу с неприятным запахом. Больной испытывает дискомфорт из-за сильного зуда и жжения в носовой полости. Заражение происходит воздушно-капельным путем, а также из-за нарушения обычных правил личной гигиены.
- Гистоплазмоз. Симптомы этого заболевания включают насморк, зуд внутри носа, а также появление ранок и язв, которые постоянно выделяют секрет.
- Аспергиллез. Это заболевание часто встречается у людей, работающих в пыльных помещениях. Оно проявляется заложенностью одной из пазух носа, где появляется грибковая горошина, которая может не проявляться долгое время. Симптомы включают головокружение, чувство удушья, кровотечение из носа и выделение слизи.
Препараты местного действия и таблетки от грибка в горле
Лечение грибковой инфекции в горле у мужчин и женщин включает применение местных и системных препаратов. При незначительных проявлениях фарингомикоза можно применять следующие антимикотические мази:
- Нистатиновая мазь – традиционное средство для лечения молочницы, вызванной дрожжеподобными грибами. Препарат не рекомендуется для применения у беременных женщин, а также у пациентов с панкреатитом и заболеваниями печени.
- Амфотерицин – эффективно уничтожает грибок в горле, независимо от типа заболевания. Мазь не рекомендуется при беременности, аллергии на компоненты и заболеваниях печени.
- Клотримазол – мощное фунгицидное средство. После проникновения в организм патогенных грибов, препарат подавляет их развитие. Не назначается беременным женщинам, пациентам с заболеваниями печени и индивидуальной непереносимостью компонентов.
- Левориновая мазь – эффективное средство для уничтожения патогенных грибов рода Кандида. Не рекомендуется при заболеваниях печени, двенадцатиперстной кишки, желудка и беременности.
- Декаминовая мазь – препарат на основе декамина с выраженным антибактериальным и фунгицидным действием. Средство не имеет противопоказаний, за исключением непереносимости компонентов.
Если у пациента обнаружена острая форма грибковой ангины, то лечение заболевания продолжается до 14 дней. При отсутствии осложнений болезнь лечат в амбулаторных условиях. Если инфекция затрагивает нижние дыхательные пути, пациента госпитализируют. Помимо местных препаратов против фарингомикоза, используют системные антимикотические средства. Их разновидности представлены в таблице:
| Группа | Действие на организм | Примеры препаратов |
| Полиены | Повреждают клеточную структуру патогенных грибов, что приводит к их гибели. |
|
| Аллиламины | Обеспечивают фунгицидное действие. Эффективны против дрожжеподобных грибов, дерматофитов. |
|
| Азолы | Угнетают развитие и распространение возбудителей заболевания по слизистой ротоглотки. |
|
Один из наиболее распространенных препаратов для лечения грибковых инфекций – Флуконазол в форме таблеток. Этот препарат редко вызывает аллергические реакции и обычно легко переносится. Дозировка и продолжительность курса лечения определяются индивидуально с учетом тяжести воспалительного процесса и возраста пациента. В случае, если стандартное лечение не приносит желаемого эффекта, врач может решить назначить пациенту Амфотерицин В внутривенно под строгим наблюдением специалистов. Для уничтожения плесневых грибов терапию можно усилить, добавив таблетки Итраконазола или Тербинофина.
Другой метод лечения грибкового поражения ротоглотки — применение антисептических растворов. Введение препаратов этой категории непосредственно в глотку помогает прекратить распространение патогенной микрофлоры. Регулярные процедуры улучшают состояние пациента и устраняют признаки отравления организма.
Необходимо подчеркнуть, что употребление антисептиков внутрь недопустимо, чтобы избежать нарушения работы пищеварительной системы. Применение препаратов этой категории следует ограничить периодом не более 5-7 дней, чтобы предотвратить адаптацию возбудителей инфекции к лекарственным средствам.
В аптеках можно найти большой выбор антисептических растворов. Для борьбы с фарингомикозом можно приобрести следующие средства:
- Йокс;
- Мирамистин;
- Люголь;
- Стоматофит;
- Гексорал;
- Хлоргексидин Биглюконат;
- Повидон-йод.
Инфекция в горле может нарушить естественный баланс микроорганизмов в организме. Для восстановления здоровья и защиты иммунитета пациентам часто рекомендуют прием пробиотиков. Однако следует быть осторожными с их использованием. Неправильное применение пробиотиков может вызвать аллергические реакции и даже привести к образованию камней в почках. При грибковом поражении горла обычно назначают следующие препараты этой группы:
- Препарат Биоспорин;
- Препарат Линекс;
- Препарат Флорин Форте;
- Препарат Бифиформ;
- Препарат Пробифор.
Для увеличения организма сопротивляемости к болезнетворным грибам при лечении фарингомикоза вместе с фунгицидными препаратами назначаются иммуномодулирующие средства. Они помогают стимулировать нейтрофилы, фагоциты, гранулоциты, способные уничтожать возбудителей грибковой инфекции в дыхательных органах. Кроме того, иммунностимуляторы содержат компоненты, усиливающие клеточный иммунитет и способствующие производству интерферона. Популярные препараты этой группы перечислены ниже:
- Препарат Лаферон;
- Препарат Амиксин;
- Препарат Имудон;
- Препарат Анаферон;
- Препарат Полудан.
Лечение народными средствами
Если симптомы грибка в носоглотке слабо выражены и заболевание протекает легко, то можно воспользоваться народными средствами для лечения. Один из эффективных рецептов заключается в том, чтобы смешать сок половины лимона и чайную ложку сока золотого уса в стакане воды. Этим раствором следует полоскать горло. По прошествии некоторого времени грибок начнет выходить в виде белых хлопьев. Также можно приготовить смесь из чайной ложки измельченной травы зверобоя и 200 мл растительного масла, и обрабатывать ею горло 3 раза в день.
В клюквенный напиток добавьте воду в равных пропорциях. Промывайте горло после еды. Для полосканий можно использовать сок каланхоэ.
Во время лечения важно придерживаться диеты. Рекомендуется включать в рацион рыбу, гречку, яйца, капусту, лук, чеснок, зелень. Не рекомендуется употреблять сладости, блюда с уксусом, дрожжи, а также избегать солений, квашеной капусты и алкоголя во время болезни.
Лечение грибкового ринита с применением народных средств дает хорошие результаты. Известно, что грибок не может развиваться в щелочной среде, именно на этом принципе основан следующий рецепт: растворите чайную ложку соды в литре теплой кипяченой воды и используйте этот раствор для промывания носа. Также полезно промывать нос отварами трав, таких как ромашка, календула, или цветы шиповника. Пораженные участки слизистой носа можно обработать соком моркови или свеклы.
Грибковое поражение в носоглотке также проявляется отечным языком, покрытым белыми отложениями. Такие же отложения наблюдаются на миндалинах и небе. Иногда возникают мелкие пузырьки. Для лечения и профилактики грибкового поражения можно использовать следующую смесь трав. Необходимо взять зверобой, календулу, мяту, листья березы и цветы черемухи в равных пропорциях и заварить эту смесь кипятком. Можно вдыхать пары, а можно прополоскать горло настоем. Методы профилактики. Основной акцент в профилактике следует сделать на укреплении иммунитета различными способами, такими как закаливание, прогулки на свежем воздухе, правильное питание. Сильный иммунитет способен надежно защитить организм от грибкового поражения.
При составлении рациона питания рекомендуется избегать острой и жесткой пищи, так как она плохо усваивается организмом и может нанести вред слизистой оболочке, открывая путь для инфекций. Полезно включать в рацион каши, пюре и супы.
Не рекомендуется употреблять антибиотики без контроля и назначения врача.
Как лечить грибок во рту
Перед тем, как начать лечение грибка в полости рта, врачу необходимо установить точный диагноз, основываясь на жалобах пациента, результате лабораторного анализа соскоба из слизистой оболочки, клиническом анализе крови и уровне сахара. После того, как картина заболевания становится ясной, дерматолог (стоматолог, пародонтолог) разрабатывает схему приема лекарства и объясняет пациенту, как лечить кандидоз. Если грибок поражает другие органы, инструкции по лечению болезни даст инфекционист или миколог. Лечение может быть общим (системным) или местным.
Метод системного лечения предполагает применение пероральных препаратов, которые оказывают воздействие на организм в целом. Эти средства способствуют излечению кандидоза в различных органах. Противогрибковые препараты подразделяются на имидазолы и полиеновые антибиотики.
К группе полиеновых антибиотиков относятся леворин и нистатин. Врач подробно объяснит, как лечить грибковое поражение в полости рта при помощи таблеток. Стандартный курс лечения составляет 10-14 дней, в течение которых необходимо ежедневно принимать по 4 таблетки после еды. Таблетки следует медленно рассасывать, чтобы обеспечить продолжительное воздействие препарата на очаги инфекции. Улучшение состояния обычно наступает к 5-му дню лечения, проявляясь в уменьшении налета и заживлении эрозий. В случае, если ожидаемого результата не достигнуто, врач может назначить прием таблеток амфоглюкамина дважды в день или введение амфотерицина внутривенно.
Препараты, относящиеся к имидазолам, включают эконазол, клотримазол, миконазол. Их обычно назначают в дозе от 50 до 100 мг ежедневно, протяженность курса составляет от 1 до 3 недель. Конкретные методы и средства лечения грибка определит врач в зависимости от возраста пациента и степени тяжести заболевания.
Эффективные средства с антимикробным и антипаразитарным действием получили положительные отзывы за возможность прекратить размножение грибков:
- Для лечения рекомендуется принимать Дифлюкан один раз в сутки в дозе от 50 до 100 мг в течение 1-2 недель;
- Флуконазол следует принимать раз в день в дозе от 200 до 400 мг;
- Декаминовую карамель рекомендуется рассасывать по 2 шт. в день в течение 2 недель;
- Низорал в таблетках назначается в дозе 200 мг ежедневно в течение 2-3 недель.
Для укрепления организма люди употребляют витамины B, C, PP. В течение месяца рекомендуется принимать глюконат кальция, который способен снизить проявление аллергии. Также для борьбы с аллергическими реакциями на грибковую активность назначают супрастин, димедрол и другие препараты. Параллельно следует принимать препараты с содержанием железа. Для более быстрого выздоровления рекомендуется прививка от кандидоза, а также препараты метилурацил и пентоксил.
Молочница у детей
Грибы кандиды могут находиться в организме человека незаметно. Избавиться от них невозможно, так как они присутствуют повсюду в окружающей среде, включая кожу человека. Заражение происходит при контакте с различными предметами, почвой, растениями и животными. У детей чаще возникают грибковые инфекции горла из-за их активности, любви к играм на улице, контакта с растениями и животными. Дети часто могут запачкать руки и не уделять им должного внимания. Это одна из причин возникновения молочницы в горле и других грибковых инфекций у маленьких детей, особенно учитывая нестабильность их микрофлоры и незрелость иммунной системы.
Молочница может появиться у младенца непосредственно после его рождения. Споры этого грибка присутствуют повсюду. Источником заражения может быть медицинский персонал роддома, больницы, окружающие ребенка люди, недостаточно дезинфицированная соска. Грибок в горле матери может передаться младенцу через поцелуй.
Симптомы молочницы включают в себя покраснение слизистой оболочки языка, миндалин и внутренней стороны щек. Появляются небольшие пузырьки, которые затем увеличиваются и превращаются в белый творожистый налет. Если не начать лечение молочницы, могут появиться эрозии и язвы. Ребенок может плохо кушать или вовсе отказываться от еды, а также становиться беспокойным. У грудничков возможно повышение температуры тела.
Однако иногда молочница может проходить незаметно, если мама уделяет достаточное внимание гигиене малыша. Чтобы предотвратить размножение кандид в горле у малыша, полезно после каждого кормления давать грудничку 1 час
л. свежей кипяченой воды или промывать рот слабым раствором соды.
Ребенок, который получает питание грудным молоком, рискует заболеть молочницей, если у матери имеется привычка употреблять большое количество сладостей или выпечки.
Для предотвращения появления кандидоза в горле у ребенка, который употребляет разнообразную пищу, рекомендуется уменьшить количество употребляемого молока, сладостей, выпечки, квашеных и острых продуктов.
Необходимо, чтобы дети употребляли достаточное количество рыбы, овощей, нежных фруктов, соков и кисломолочных продуктов.
Несмотря на то, что существует множество народных рецептов, самостоятельно лечить молочницу в горле у ребенка не рекомендуется. Это связано с тем, что грибковая инфекция может вызвать серьезные осложнения, такие как образование язвочек с кровотечением, особенно в случае запущенной формы заболевания. Только педиатр может определить оптимальный способ лечения грибка в горле, чтобы предотвратить заражение других органов или переход заболевания в хроническую форму.
Когда у ребенка появляется грибковое воспаление в горле, это часто приводит к развитию грибкового тонзиллита, который может проявиться в виде острой ангины.
Разновидности
Для того чтобы грибковая инфекция поразила ротовую полость, необходимо, чтобы сработало несколько факторов одновременно. В зависимости от общего состояния человека, страдающего от грибковой инфекции, кандидоз полости рта может проявляться по-разному и затрагивать разные участки слизистой оболочки.
Молочница чаще возникает у грудных детей и пожилых людей. Когда организм ослаблен частыми простудами, у пациента есть хронические заболевания, и тогда иммунная система не способна противостоять патогенным микроорганизмам, что приводит к поражению ротовой полости кандидозом.
Ротоглоточная молочница
Чаще всего ротоглоточный кандидоз развивается после применения антибиотиков. Если не соблюдать рекомендуемую дозировку или принимать препараты в течение длительного времени, полезная микрофлора в полости рта подавляется под воздействием лекарств, и ее место занимают патогенные микроорганизмы. Именно поэтому пациенты, которым была назначена агрессивная терапия, становятся носителями ротоглоточного кандидоза.
Обнаружить молочницу на ранней стадии развития очень сложно, так как нет явных признаков, и участки с серо-белым налетом не превышают 3 мм.
В данном случае нет необходимости в лечении. После прекращения приема антибактериальных препаратов, иммунитет организма сможет самостоятельно победить молочницу. При тяжелом течении заболевания рекомендуется применять противогрибковые препараты, использовать антисептические средства для устранения очагов грибкового поражения и придерживаться специальной диеты.
Микоз десен
У молодых матерей часто возникает ситуация, когда у их младенцев появляется белый налет во рту, и они предполагают, что это остатки свернувшегося молока. Однако на самом деле в большинстве случаев этот признак указывает на наличие кандидоза десен. Это довольно распространенное явление, связанное с заражением грибками Кандида плода во время беременности или в процессе родов.
У взрослых также возможны проблемы с кандидозом десен. Грибковое заболевание может появиться из-за недостаточной гигиены полости рта, курения или применения оральных контрацептивов. Люди, использующие зубные протезы, также могут ощущать дискомфорт при этом грибковом заболевании.
Поражение уголков рта
Грибковая инфекция редко влияет на уголки рта. Человек замечает, что в пораженной области начинают появляться мелкие трещинки, которые со временем начинают распространяться.
Иногда пораженные участки кожи приобретают белый налет. При развитии грибковой инфекции могут появиться трещины и кровоточить при открытии рта, что вызывает дискомфорт у пациента. Лечение назначается опытным специалистом. Чаще всего кандидоз уголков рта поддаётся лечению с использованием мазей и кремов (например, Нистатин, Флуконазол). Также врач может посоветовать приём витаминов и иммуностимуляторов.
Этиология
Инфекция в горле чаще всего связана с кандидозом, который поражает слизистую оболочку гортани и глотки. Кандидоз вызывается грибами рода Кандида, которые представляют собой дрожжеподобные микроорганизмы, обитающие в различных областях человеческого организма. Снижение общей иммунной защиты, вызванное применением антибиотиков в течение длительного времени, нарушает баланс местной микрофлоры и способствует развитию данной патологии.
Существует множество причин и факторов, которые могут способствовать развитию грибковой инфекции в горле:
- Заболевания эндокринной системы, такие как сахарный диабет, гипотиреоз и гиперфункция надпочечников;
- Наследственные и приобретенные нарушения иммунной системы;
- Дисбактериоз кишечника и нарушения работы желудочно-кишечного тракта;
- Раковые заболевания;
- Нарушения обмена веществ;
- Использование зубных протезов, наличие кариеса;
- Ингаляционное применение кортикостероидов;
- Заболевания крови;
- Недостаток витаминов и минералов;
- Младенческий возраст, недоношенность;
- Неправильное лечение заболеваний уха, горла и носа;
- Длительное применение цитостатиков и гормональных препаратов, включая оральные контрацептивы;
- Трансплантация органов и тканей;
- Инвазивные методы диагностики и лечения;
- Длительное и неправильное использование местных антисептических средств, таких как спреи, пастилки и леденцы;
- Период менопаузы у женщин;
- Мелкие травмы слизистой оболочки горла;
- Вдыхание загрязненного пылью воздуха, паров кислот и щелочей;
- Курение;
- Потребление горячей пищи и крепких спиртных напитков;
- Рефлюкс-эзофагит.
Наиболее часто встречающимся видом грибковой инфекции является кандидоз. Это инфекция, которая развивается в различных клинических формах и проявляется как поверхностный микоз, поражающий слизистую оболочку глотки и гортани. Грибы из этой группы представляют собой крупные клетки, похожие на дрожжи, округлой, эллипсоидной или овальной формы.
Кандиды — это аэробные микроорганизмы, которые могут развиваться при температуре от 22 до 37 градусов. Они успешно размножаются как в жидких, так и в твердых питательных средах, таких как Сабуро, агар с добавлением сусла, глюкозы, а также на специальных коммерческих средах, например, Кандиселект и хромоагар. Для предотвращения роста сопутствующей микрофлоры в питательные среды добавляют антибиотики и противоплесневые вещества. Для изучения биохимических свойств кандид используются среды Гисса с различными видами сахаров.
Грибы рода Кандида очень чувствительны к высокой температуре и давлению, ультрафиолетовому и солнечному излучению, хлорсодержащим дезинфицирующим средствам, фенолу, кислотам, красителям, спирту и ртути. Кандиды встречаются повсюду и могут быть обнаружены в организме человека, на предметах окружающей среды, в медицинских учреждениях, парикмахерских, банях, детских учреждениях.
Инфекция передается от больных людей к здоровым через контактно-бытовые, алиментарные и воздушно-капельные пути, а также через загрязненные продукты питания, поцелуи и предметы общего пользования. В последнее время также отмечается передача возбудителя от инфицированной матери плоду или новорожденному ребенку. Внутрибольничное заражение кандидозом возможно через руки медицинского персонала, катетеры, загрязненные растворы и инструменты.
Помимо основных клинических проявлений, у взрослых и детей также встречается состояние здорового носителя кандидоза. Это состояние может быть временным или постоянным.
Воспаление горла, вызванное грибковой инфекцией, может проявляться не только как кандидоз, но также как актиномикоз или лептотрихоз. При лептотрихозе на слизистой оболочке глотки могут появиться плотные образования серого или желтого цвета в форме шипов, а при актиномикозе – бугристые инфильтраты темно-красного оттенка.
Какие еще грибковые инфекции могут поражать горло
Не только кандидоз может вызывать воспаление слизистой оболочки ротоглотки. Существует множество других грибковых инфекций, способных проникнуть в ткани верхних дыхательных путей. При этом так называемые «некандидозные» грибковые инфекции встречаются очень редко, но они представляют гораздо большую опасность, чем кандидоз. Рассмотрим некоторые из них:
- Аспергиллез
Существует более 160 разновидностей гриба Аспергилус, и только 10 из них доказано как патогенные для человека. Аспергиллы обитают в больших количествах в окружающей среде, такой как почва, опавшая листва и гниющие растения. Споры этих грибов легко распространяются, и люди часто вдыхают их, находясь на свежем воздухе. Тем не менее, человечество никогда не сталкивалось с эпидемиями аспергиллеза, что свидетельствует о том, что микозы являются опортунистическими заболеваниями, которые развиваются только у людей с ослабленным иммунитетом. Несмотря на это, количество случаев аспергиллеза постепенно увеличивается. В настоящее время аспергиллез занимает второе место в мире по распространенности среди грибковых инфекций (на первом месте находится кандидоз).
Вдыхание спор аспергилл может привести к развитию грибковой инфекции в любой части верхних дыхательных путей, включая полость рта, пазухи носа и трахею.
Многие люди путают эту болезнь с другими ОРЗ, такими как бактериальный синусит, ларингит и другие. При этом у пациента наблюдается незначительное повышение температуры тела, а отхаркиваемая мокрота или выделения при насморке приобретают зеленоватый или темный оттенок и имеют неприятный запах.
- Бластомикоз
Бластомикоз — это системное грибковое заболевание, которое влияет на кожу и слизистую оболочку ротоглотки, а затем распространяется на лимфатическую ткань и внутренние органы. Как и в случае с аспергиллезом, заражение происходит через вдыхание спор, которые обитают в почве. Бластомикоз гортани может проявляться как изолированное заболевание или совместно с поражением кожи. На коже бластомикоз проявляется в виде красной папулезной сыпи по всему телу. Папулы сливаются между собой и покрываются гнойными корками. Наличие сыпи на коже значительно упрощает диагностику. Изолированную форму бластомикоза гортани часто путают с другими заболеваниями, такими как бактериальный или вирусный ларингит и другие.
- Криптококкоз
Споры грибка Криптококкус могут быть обнаружены в различных местах, таких как почва, гниющие овощи, экскременты голубей, канареек, волнистых попугаев и других птиц, иногда они встречаются в фекалиях кошек, лошадей, собак (при этом животные не болеют). Вдыхание этих спор может привести к развитию криптококкоза, заболевания, которое может поражать слизистые оболочки верхних и нижних дыхательных путей, а также органы нервной системы, включая головной или спинной мозг.
Криптококкоз — хитроумная инфекция, которая может длиться длительное время, не проявляясь никакими симптомами. Признаки заболевания появляются постепенно на слизистой оболочке пораженного органа, такого как глотка, гортань, рот и т.д., в виде узелков, язв и папиллом. Болезнь продолжает прогрессировать, углубляя язвы и разрушая мягкие ткани, включая миндалины, слизистую оболочку, мягкое небо, а иногда даже кости. Одним из характерных признаков криптококкоза является то, что температура тела больного остается нормальной, независимо от тяжести заболевания. Изолированный криптококкоз слизистой оболочки успешно поддается лечению.
Важно отметить, что заболевание криптококкозом горла редко возникает самостоятельно; чаще всего оно развивается в результате распространения инфекции из легких, мозга или других внутренних органов.
- Гистоплазмоз
Грибковая инфекция, вызванная микозом системного типа, вызывается грибком из семейства Гистоплазма. Попадание спор этого грибка в организм происходит при вдыхании их из почвы. В первую очередь поражается глотка, десна и небо. На слизистой образуются выпуклые обширные язвы. Инфекция способна распространяться вниз по дыхательным путям.
- Зигомикоз
Мукор и Ризопус — наиболее распространенные представители зигомицетов. Эти микроорганизмы встречаются повсеместно — они обитают в почве и разлагающихся продуктах питания. У здоровых людей споры этих грибов практически всегда присутствуют в носоглотке, не вызывая заболеваний. Однако при зигомикозе необходимо пройти тест на ВИЧ-инфекцию (ведь люди с нарушенной иммунной системой часто страдают от этого заболевания). Болезнь протекает очень тяжело. При поражении глотки происходит разрушение мягких тканей, а затем и костей.
Инфекции горла, вызванные грибками, являются редкими, но серьезными заболеваниями. Важно отметить, что они возникают только у людей с сильно ослабленной защитой организма.
Кандидоз слизистой оболочки полости рта и глотки
Кандидоз представляет собой заболевание кожи, слизистых оболочек полости рта, глотки и внутренних органов, вызываемое дрожжеподобным грибом Candida albicans. Развитию кандидоза способствуют гипопаратиреоз, нарушения функции печени, поджелудочной железы, углеводного обмена, а также дисбактериоз кишечника, возникающий чаще всего при длительном лечении антибиотиками и кортикостероидами. Нередко заболевание возникает при травматических повреждениях слизистой оболочки и при воздействии вредных веществ в атмосфере.
Кандидоз, также известный как дрожжевой стоматит или молочница, чаще всего встречается у грудных детей и пожилых людей, особенно у тех, кто страдает хроническими и тяжелыми заболеваниями. Вначале появляется ощущение сухости в полости рта, затем появляются множественные точечные налеты беловатого цвета на небе, языке и щеках. При их объединении образуются крупные беловато-серые пленки, которые позднее легко отделяются; под ними обнаруживаются поверхностные эрозии, имеющие опалесцирующий вид («сухие»). Существует несколько форм кандидоза полости рта и глотки.
Резкая вариация — острый псевдомембранозный кандидоз (молочница, соормикоз), наиболее распространенная форма данного заболевания. Характеризуется появлением белых или синевато-белых отметин на слизистой оболочке полости рта.
Хронический гиперпластический кандидоз проявляется появлением плотно спаянных бляшек на гиперемированной слизистой оболочке полости рта и глотки. Часто налет наблюдается на спинке языка в области, характерной для ромбовидного глоссита. Пациенты ощущают сухость в полости рта, постоянно хотят увлажнить рот, при этом также отмечается уменьшение слюнотечения, что усиливает сухость полости рта.
Постоянный атрофический кандидоз отличается отсутствием сосочков на верхней части языка или проявляется как атрофический ромбовидный глоссит.
Ангина, вызванная кандидозом, проявляется появлением белых блестящих «пробок» в глубине фолликулов миндалин небных дуг. Миндалины становятся гиперемированными, но не вызывают боли. Эта разновидность кандидоза обычно характеризуется длительным течением, при этом температура тела не повышается, и нет болезненности при глотании.
Хронический генерализованный (гранулематозный) кандидоз обычно возникает у детей с нарушенным иммунитетом и недостаточной функцией паращитовидных желез. Этот вид заболевания обычно проявляется в раннем детском возрасте в форме молочницы, кандидозного хейлита, а также поражением гортани, трахеи, бронхов, мелкоочаговой пневмонии, иногда могут образовываться каверны.
Исцеление состоит в назначении препаратов противогрибковой терапии (например, нистатина, леворина, низорала и других). При хроническом кандидозе проводится иммунотерапия. Пациентам, которые длительное время принимали антибиотики широкого спектра действия и кортикостероиды, для профилактики кандидоза рекомендуется применение нистатина. Для локального лечения назначается обработка пораженных участков раствором микостатина на глицерине.
Прогноз обычно обнадеживающий. Могут возникнуть повторные проявления.
Частые вопросы
Какие симптомы грибковых заболеваний в горле могут возникать?
Симптомы грибковых заболеваний в горле могут включать в себя зуд, боли при глотании, покраснение и отечность слизистой оболочки, появление белого налета или бляшек в горле.
Как проводится лечение грибковых заболеваний в горле?
Лечение грибковых заболеваний в горле может включать применение противогрибковых препаратов в виде таблеток, растворов для полоскания горла или спреев, а также местное лечение антимикотическими препаратами.
Полезные советы
СОВЕТ №1
Обратитесь к врачу для точного диагноза. Симптомы грибковых заболеваний в горле могут быть похожи на другие заболевания, поэтому важно получить профессиональную консультацию.
СОВЕТ №2
Следуйте рекомендациям врача относительно лечения. Обычно грибковые инфекции в горле лечатся антимикотическими препаратами, такими как лизиноприл или флуконазол, назначенными врачом.
СОВЕТ №3
Соблюдайте гигиену полости рта. Регулярное чистка зубов, использование антисептических полосок для горла и употребление пресной воды могут помочь в борьбе с грибковыми заболеваниями в горле.